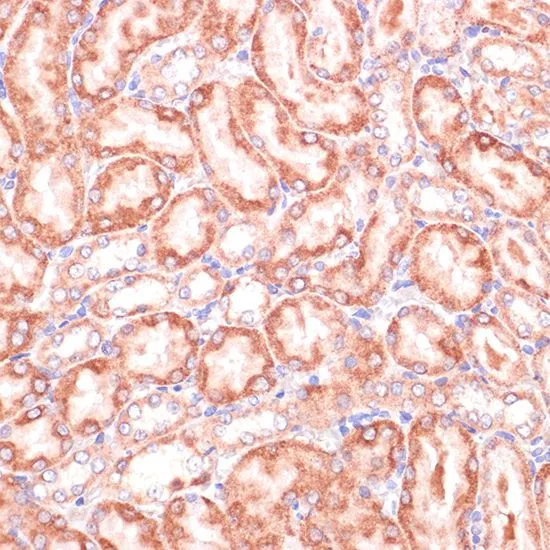

WB analysis of various sample lysates using GTX55744 PGD antibody. Dilution : 1:1000 Loading : 25microg per lane
PGD antibody
GTX55744
ApplicationsWestern Blot, ImmunoHistoChemistry, ImmunoHistoChemistry Paraffin
Product group Antibodies
TargetPGD
Overview
- SupplierGeneTex
- Product NamePGD antibody
- Delivery Days Customer9
- Application Supplier NoteWB: 1:500 - 1:2000. IHC-P: 1:50 - 1:200. *Optimal dilutions/concentrations should be determined by the researcher.Not tested in other applications.
- ApplicationsWestern Blot, ImmunoHistoChemistry, ImmunoHistoChemistry Paraffin
- CertificationResearch Use Only
- ClonalityPolyclonal
- ConjugateUnconjugated
- Gene ID5226
- Target namePGD
- Target descriptionphosphogluconate dehydrogenase
- Target synonyms6PGD, 6-phosphogluconate dehydrogenase, decarboxylating
- HostRabbit
- IsotypeIgG
- Scientific Description6-phosphogluconate dehydrogenase is the second dehydrogenase in the pentose phosphate shunt. Deficiency of this enzyme is generally asymptomatic, and the inheritance of this disorder is autosomal dominant. Hemolysis results from combined deficiency of 6-phosphogluconate dehydrogenase and 6-phosphogluconolactonase suggesting a synergism of the two enzymopathies. Several transcript variants encoding different isoforms have been found for this gene. [provided by RefSeq, Jan 2015]
- Storage Instruction-20°C or -80°C,2°C to 8°C
- UNSPSC12352203